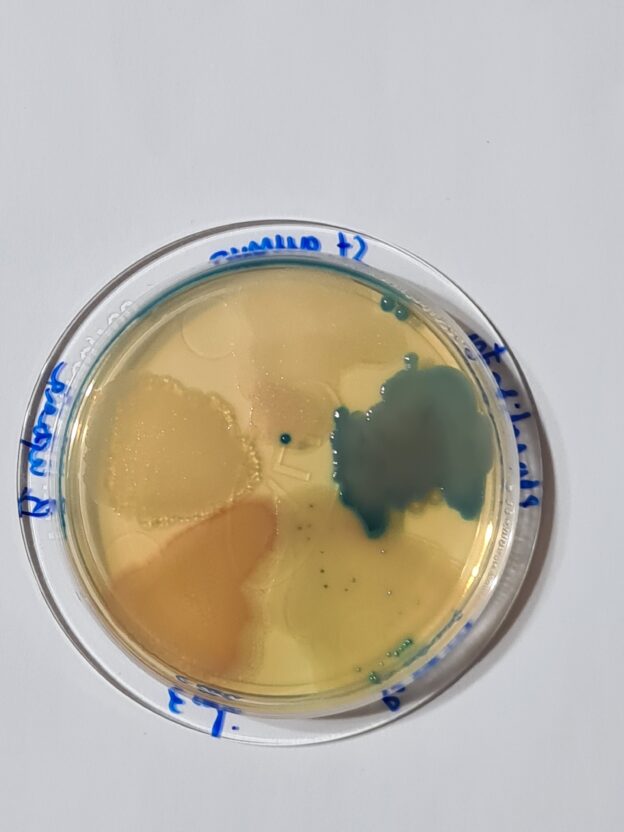

Medios Cromogénicos CROMOKIT®: La Gama Pionera que Simplifica la Identificación
En Laboratorios MICROKIT® somos pioneros en el diseño y fabricación de medios cromogénicos. Desde la década de los 90, hemos desarrollado la gama más completa y veterana del mercado mundial, diseñada y fabricada en España.
Los medios CROMOKIT® son esenciales para el análisis microbiológico de alimentos, aguas, cosméticos, superficies y aire, y su principal ventaja es ahorrar tiempo y recursos en las costosas galerías de identificación.
Ventajas Funcionales de la Tecnología Cromogénica
Nuestros medios enzimáticos ofrecen una especificidad y velocidad que superan a los medios tradicionales:
La Oferta Más Completa del Mercado
Nuestra experiencia nos permite ofrecer la gama CROMOKIT® en todos los formatos posibles para adaptarse a las necesidades operativas de su laboratorio:
- Medio Base: Versión deshidratada.
- Formato Preparado: Tubos, frascos, ampollas MF, PLAQUIS® herméticas y kits P/A (Presencia/Ausencia).
Consulte la gama más completa del mundo de agares cromogénicos:
https://www.microkit.es/pdf/CROMOKIT-2021.pdf
Y la gama más completa del mundo de caldos cromogénicos:
https://www.microkit.es/pdf/KITS-PA-VIALES-POLVO-CALDOS-CROMOGENICOS-2021.pdf
Si desea más información sobre nuestros medios CROMOKIT ® no dude en contactar con nosotros a través de nuestro correo electrónico microkit@microkit.es, o por teléfono en el nº 91-897 46 16.

Hola buenas tardes mi nombre es Dania Gomez y trabajo para la empresa Metodos Rapidos aquí en Mexico un favor me pudiesen enviar la información técnica del los kits de FPA905 y FPA907 por favor muchas gracias
Buenos días
Respondemos a su consulta desde nuestro correo general.
Muchas gracias por visitar nuestro blog y contactar con nosotros. Un cordial saludo
tienen algun distribuidor en Mexico
Buenos días
Respondemos a su consulta desde nuestro correo general.
Muchas gracias por visitar nuestro blog y contactar con nosotros. Un cordial saludo
Información sobre algún distribuidor en México
Buenos días
Respondemos a su consulta desde nuestro correo general.
Muchas gracias por visitar nuestro blog y contactar con nosotros. Un cordial saludo
HOLA, TIENE DISTRIBUIDORES AQUI EN MEXICO?
Buenos días
Respondemos a su consulta desde nuestro correo general.
Muchas gracias por visitar nuestro blog y contactar con nosotros. Un cordial saludo
Tienen distribuidores en México?
Sí, puedes consultarlo en export@microkit.es, gracias!
Sí, por favor preguntar en export@microkit.es
Hola buen día. Tienen distribuidor en México. Saludos
Buenos días, si: Metodos Rapidos SA de CV
Buenas tardes, ¿tienen distribuidores en México?
Sí, solo tienes que preguntárnoslo en export@microkit.es, gracias!